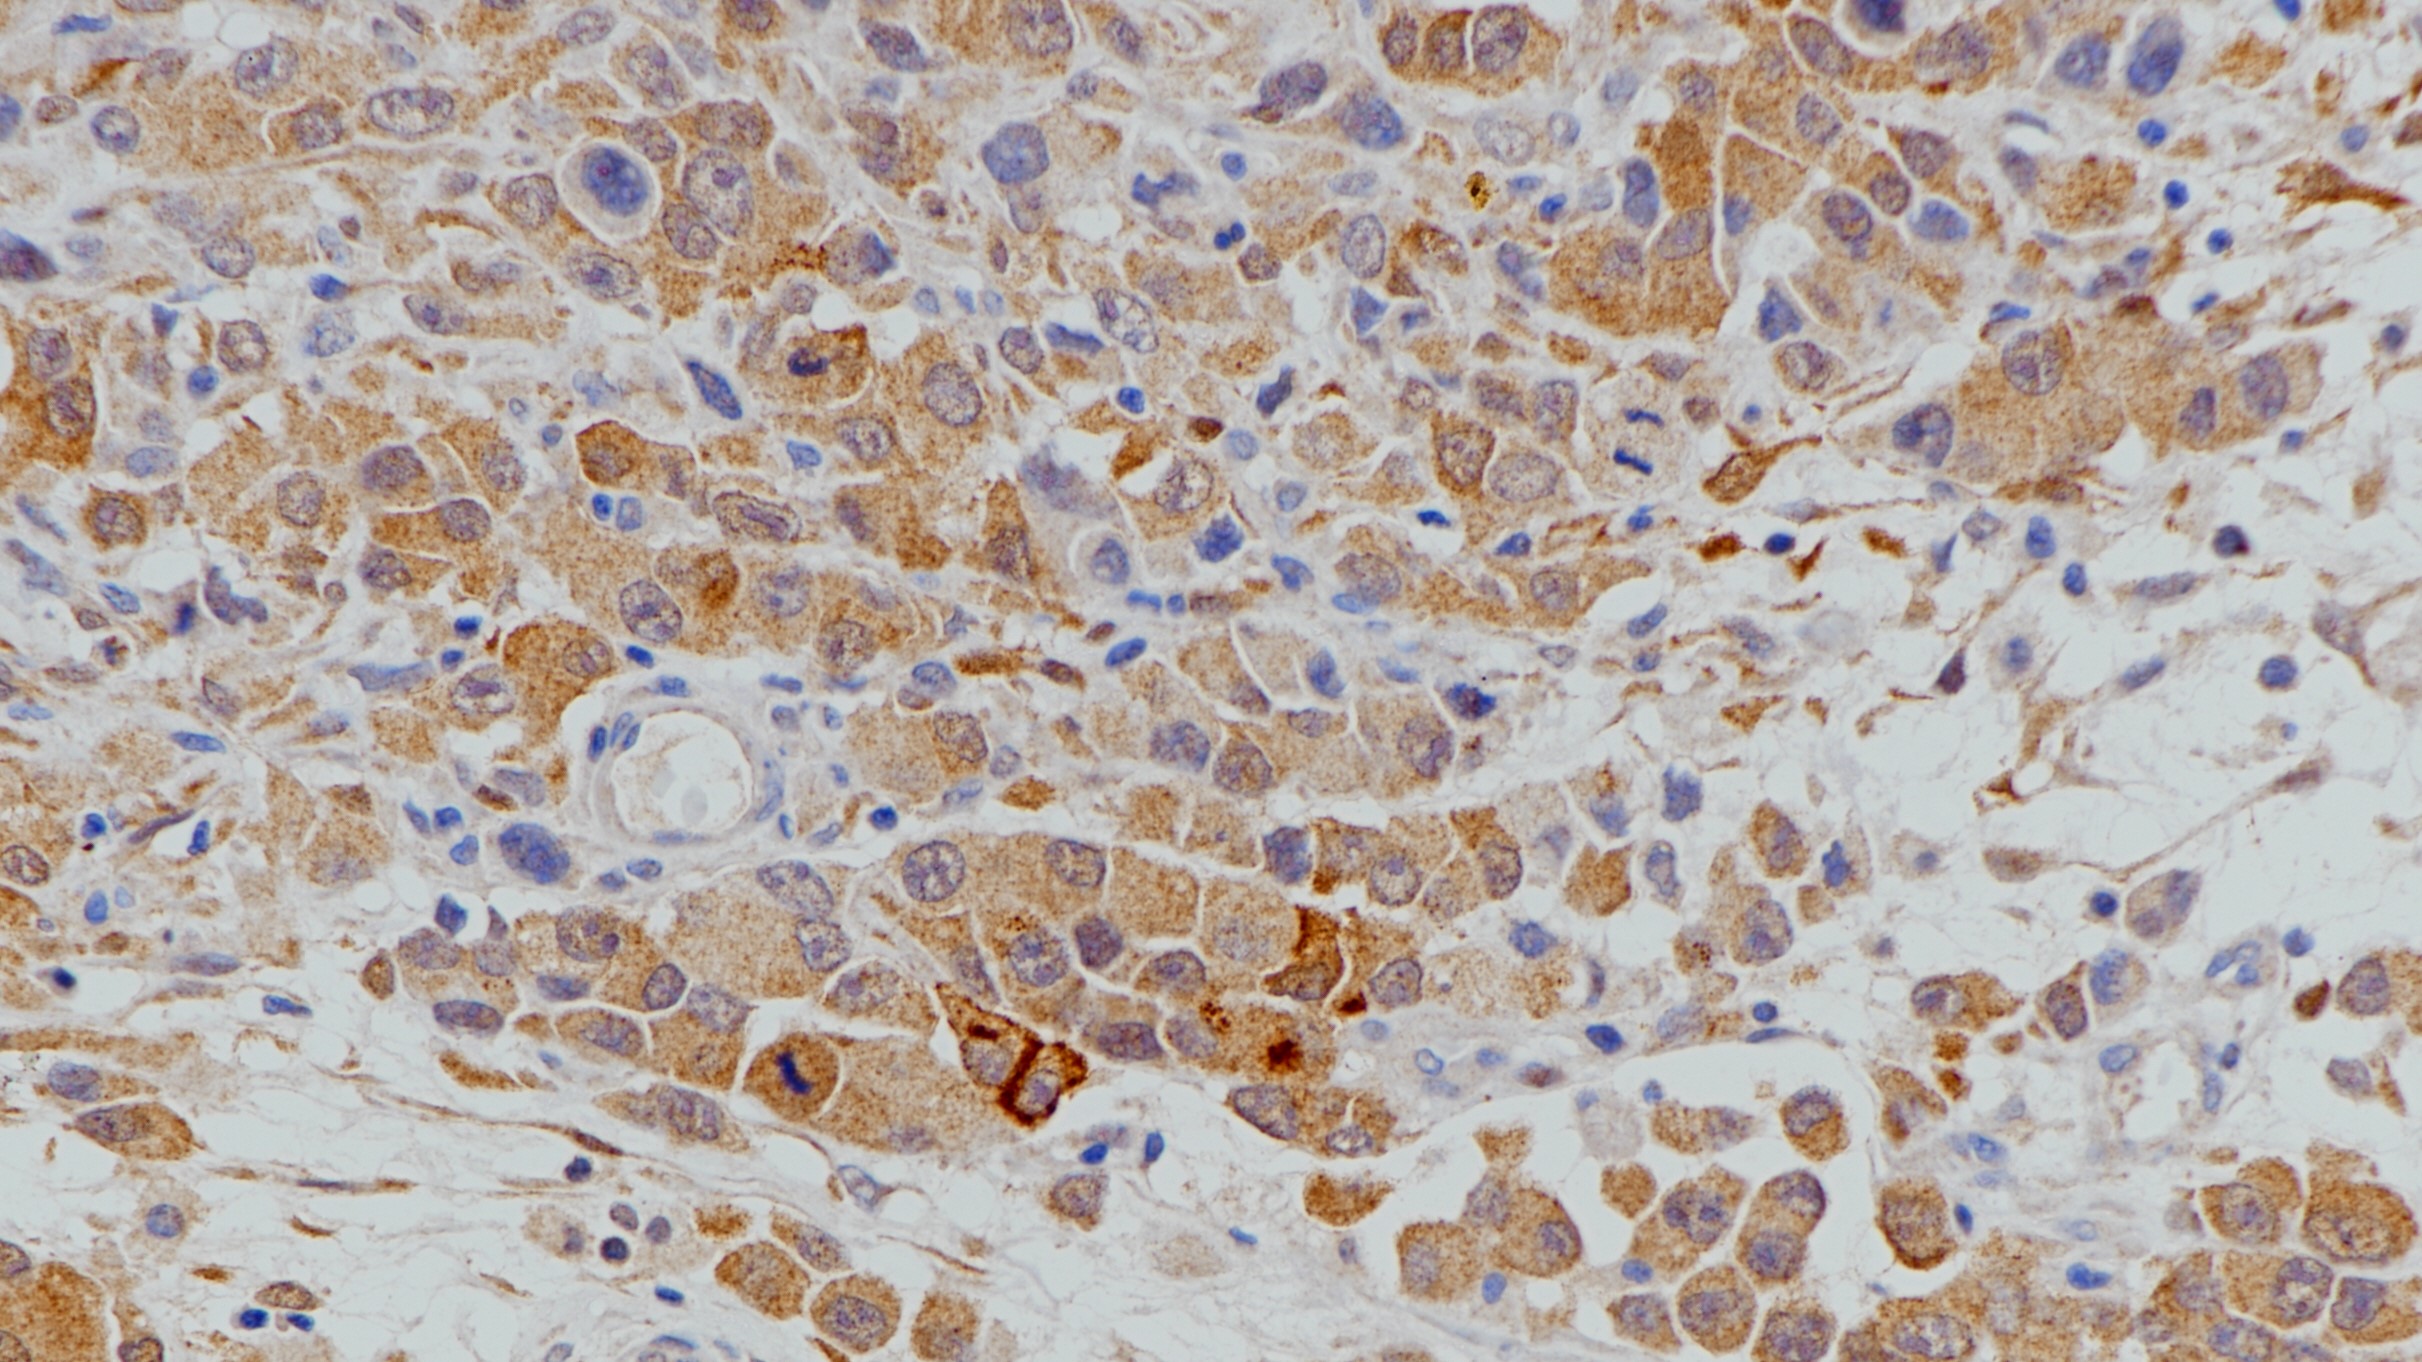
间皮瘤Calretinin(poly)染色

产品中心

Calretinin(poly)弥漫大B细胞淋巴瘤 阴性组织染色
间皮瘤Calretinin(poly)染色
Calretinin 兔多克隆抗体
Calretinin是分子量为29 kDa,由 CALB2 基因编码的 EF 手形家族的一种的钙结合蛋白。Calretinin在中枢神经系统和周围神经系统中均有表达,并在听觉神经元中表达丰富。Calretinin可用于区别上皮间皮瘤和腺癌的鉴别诊断,也可用于区分造釉细胞瘤和角化性囊性牙源性肿瘤的诊断,在先天性巨结肠病中用于评估肠粘膜下“肥大神经丛”。
Specifications
- 产品注册名称
- Calretinin抗体试剂(免疫组织化学)
- 目录号
- I1144
- 克隆号
- poly
- 亚细胞定位
- 细胞核,细胞质
- 阳性对照
- 间皮瘤
- 修复方式
- HIER
- 组织类型
- FFPE
- 规格
- 工作液:1.5mL/7mL
- 用途
- NMPA IVD
Applicable platform
- Biolynx平台
- Leica平台
- Roche平台
- Dako平台
Reference
1.Expression of calretinin in odontogenic keratocysts and basal cell carcinomas: A study of sporadic and Gorlin-Goltz syndrome-related cases[J]. Anna Maria Cesinaro,Giammarco Burtini,Antonino Maiorana,Giulio Rossi,Mario Migaldi. Annals of Diagnostic Pathology.
2.Serum calretinin as an independent predictor for platinum resistance and prognosis in ovarian cancer.[J]. Link Theresa,Passek Simon,Wimberger Pauline,Frank Kerstin,Vassileva Yana Damyanova,Kramer Michael,Kuhlmann Jan Dominik. International journal of cancer. 2020(9)
3.中华医学会.《临床技术操作规范·病理学分册》.人民军医出版社,2004.


